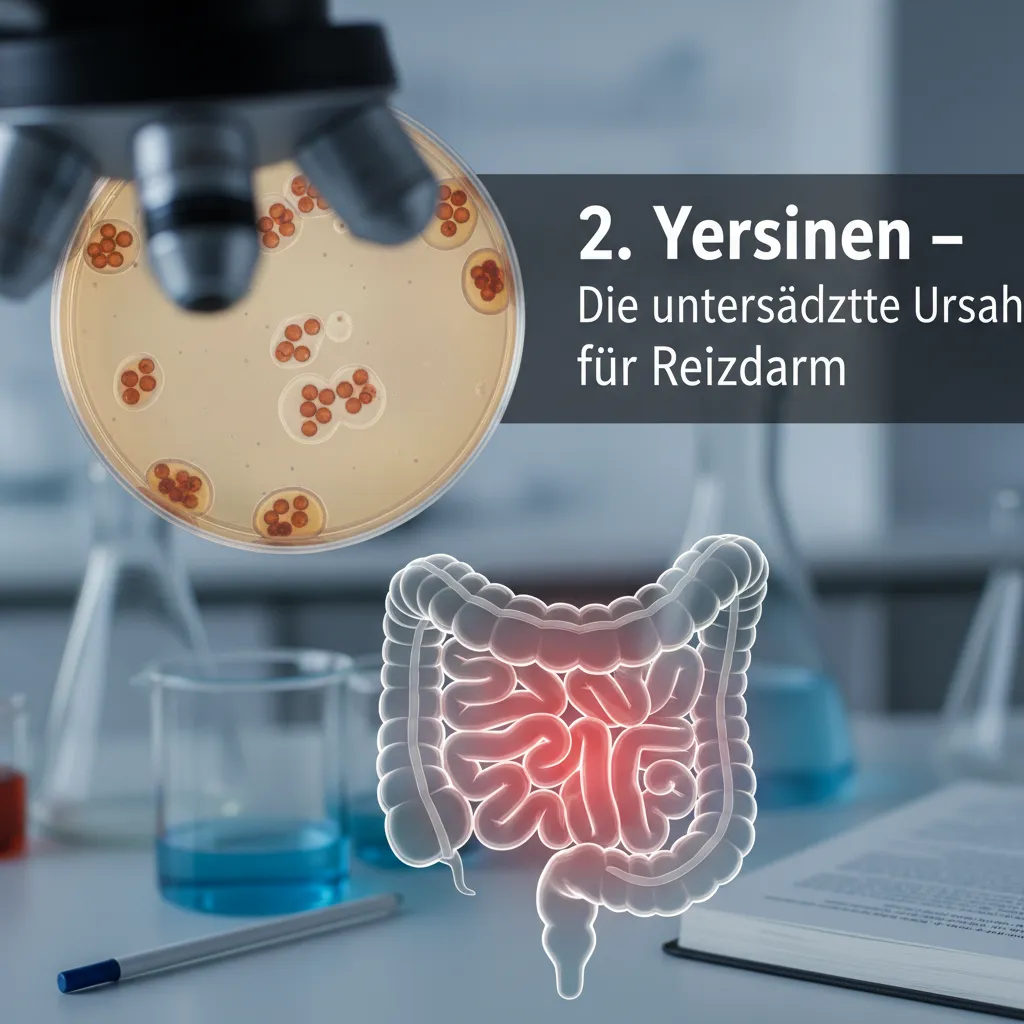
6. Fortschritte und Alltag: Von Essensängsten zu neuem Lebensgefühl

Wussten Sie, dass eine gezielte Ernährungsumstellung beim Reizdarmsyndrom wahre Wunder wirken kann? Ich erzähle Ihnen die Geschichte von Silvia, die nach Jahren der Quälerei endlich wieder Genuss am Essen und Lebensfreude gefunden hat – dank der Low-FODMAP Diät und einer individuellen Strategie.
1. Silvias Geschichte: Wenn der Darm den Alltag bestimmt
Mein Name ist Silvia, ich bin 58 Jahre alt und lebe in Ganderkesee bei Bremen. Seit drei Jahren leide ich an einem schweren Reizdarmsyndrom – mein Reizdarm-Score lag zu Beginn bei 470 von 500 Punkten. Die Reizdarmsyndrom Symptome wie starke Bauchschmerzen, Durchfall und Verstopfung bestimmen meinen Alltag. „Die Bauchschmerzen machen mich müde, kaputt, energielos, die rauben mir unheimlich viel Kraft.“ Auch Essensängste schränken meine Lebensqualität stark ein. Trotz sportlichem Lebensstil und verschiedener Therapieversuche, darunter Medikamente und Nahrungsergänzungen, blieb nachhaltige Erleichterung aus. Die Belastung wirkt sich auf meinen Beruf und mein soziales Umfeld aus. IBS Symptom Management und Verdauungskomfort verbessern sind für mich tägliche Herausforderungen, da die Symptome ständig wechseln und unvorhersehbar sind.
2. Yersinien – Die unterschätzte Ursache für Reizdarm
Als Expertin für Magen-Darmerkrankungen weiß Dr. Viola Andresen, wie wichtig es ist, Reizdarmsyndrom Ursachen genau zu prüfen. Sie vermutet bei Silvia, dass eine Yersinien-Infektion hinter ihren Beschwerden steckt. Yersinien sind Bakterien, die durch Rohmilch, Käseprodukte oder rohes Schweinefleisch übertragen werden können. Besonders nach Reisen oder dem Verzehr solcher Lebensmittel kann eine Magen-Darminfektion entstehen. „
Das Problem mit diesen Darminfektionen durch solche Bakterien wie Jersinien ist, dass sie leider ein Reizdarmsyndrom auslösen können.
“ – Viola Andresen. Infektionen wie diese werden oft unterschätzt, können aber langfristige Darmprobleme verursachen. Eine frühzeitige Diagnose und gezielte Behandlung sind entscheidend, um chronische Beschwerden zu vermeiden und die Lebensqualität zu verbessern.
3. Die Low-FODMAP Diät: Ein Plan voller Herausforderungen und Chancen
Die Low-FODMAP Diät ist das Herzstück bei Reizdarm-Beschwerden – sie verlangt Disziplin und Wissen. FODMAPs sind fermentierbare Zucker, die Blähungen, Bauchkrämpfe und Durchfall verursachen können. Silvia folgte einer strengen Low-FODMAP Eliminierungsdiät über mehr als ein Jahr:
„Foodmap hat mir unser Internist im Krankenhaus empfohlen. Aber ich habe das so perfektioniert und zu lange durchgehalten.“
Die empfohlene Eliminierungsdiät Phase beträgt jedoch nur 4 bis 8 Wochen, um Mangelernährung zu vermeiden. Besonders tückisch sind versteckte FODMAP-Quellen wie Dinkel oder Kräutertees bei langer Ziehzeit. Eliminierung allein reicht nicht – der richtige Wiedereinstieg ist entscheidend. Hier hilft ein Ernährungsberater, um die Ernährung gezielt anzupassen und langfristig Beschwerden zu lindern.
4. Reintroduktion: Schrittweiser Wiedereinstieg als Schlüssel zum Erfolg
Nach der Eliminierungsphase folgt die Reintroduktionsphase. Hier teste ich einzelne Reintroduktionsphase Lebensmittel – wie Silvia mit Laktose im Naturjoghurt – in kleinen Portionen. Alle zwei bis drei Tage erhöhe ich die Menge langsam. Ein Symptomverfolgung Tagebuch hilft mir, individuelle Verträglichkeit und Beschwerden genau zu dokumentieren. So erkenne ich, dass oft schon kleine Mengen verträglich sind. Das gibt Sicherheit:
„Ich habe das Gefühl, dass ich so langsam die Kontrolle über das Essen wiederbekomme.“ – Silvia
Durch diese Methode kann ich einen personalisierten Ernährungsplan entwickeln und mein Darmmikrobiom fördern. Wichtig ist auch, psychische Faktoren zu beachten:
„Ein Darm reagiert sehr empfindlich auf Angst; das kann Beschwerden verschlimmern.“ – Viola Andresen
5. Psychische Komponenten und Darmhypnose: Essen ohne Angst genießen
Die Behandlung von Reizdarm (IBS) umfasst mehr als nur Ernährung. Angst vor dem Essen kann durch die enge nervale Verbindung zwischen Darm und Gehirn die Beschwerden verstärken. Hier setzt die Darmhypnose an: Durch gezielte Entspannungstechniken und die Vorstellung eines sicheren Ortes – wie es Silvia in ihrer Hypnosebehandlung erlebte – kann das Nervensystem beruhigt und die Verdauung harmonisiert werden. Psychotherapeutin Juliane Neumeyer arbeitet mit heilsamen Bildern für mehr Entspannung. Begleitend half Psychotherapie bei Reizdarm, emotionale Belastungen zu verarbeiten. Erste Erfahrungen zeigen: „Das war so nach den Wochen und Monaten das i-Tüpfelchen, was mich noch ein Stück weitergebracht hat.“ – Silvia. Die Darm-Hirn-Achse rückt so in den Fokus moderner IBS Symptom Management-Strategien.
6. Fortschritte und Alltag: Von Essensängsten zu neuem Lebensgefühl
Nach zwei Monaten Low-FODMAP-Diät konnte ich wieder spontan planen und aktiv sein. Die Bauchschmerzen wurden deutlich weniger, meine Kraft stieg spürbar. Immer mehr verträgliche Lebensmittel wie Kohlgemüse, Heidelbeeren, Zucchini, Tofu und Feta bereichern meinen Langzeit Ernährungsplan. Ich habe sogar an Gewicht und Lebensfreude gewonnen, koche und backe jetzt neue Rezepte wie Buchweizenkuchen. Mein sozialer Alltag mit Familie und Freunden ist wieder möglich – ein großer Schritt für meinen Verdauungskomfort.
| Reizdarm-Score | Verbesserung | Verträgliche Lebensmittel |
|---|---|---|
| 110/500 | 360 Punkte | Heidelbeeren, Zucchini, Tofu, Feta, u.v.m. |
„Das ist der Wahnsinn, das sind Werte, die schon gesunde Menschen angeben.“ – Viola Andresen
„Ich habe das Gefühl, die Kontrolle über das Essen wiederzubekommen.“ – Silvia
7. Fazit: Mit Geduld und Zielsetzung zurück zur Lebensfreude
Die Reizdarmsyndrom Behandlung verlangt einen ganzheitlichen Ansatz – Ernährung und Psyche sind gleichermaßen wichtig. Der Low-FODMAP Diät Plan ist effektiv, wenn er strukturiert und individuell angepasst wird. Die schrittweise Wiedereinführung von Lebensmitteln und psychische Unterstützung, etwa durch Darmhypnose, helfen, den eigenen Weg zu finden. Silvias Geschichte zeigt: Mit Geduld, professioneller Begleitung und einem personalisierten Ernährungsplan ist ein Neustart möglich. Erfolge brauchen Zeit, doch sie bringen Hoffnung und neue Lebensfreude. Wie Silvia sagt:
„Das Ergebnis bedeutet, dass mein komplettes Privatleben wieder freier geworden ist.“
Auch ihre Ärztin ist überzeugt:
„Ich bin sehr optimistisch, dass es noch besser wird.“
Individuelle Lösungen und langfristige Betreuung sind der Schlüssel zum Erfolg.
TL;DR: Die Low-FODMAP Diät kann die Beschwerden bei Reizdarmsyndrom effektiv lindern. Ein strukturierter Plan mit Eliminierung, Reintroduktion und personalisierter Ernährung gibt Betroffenen neue Lebensqualität.